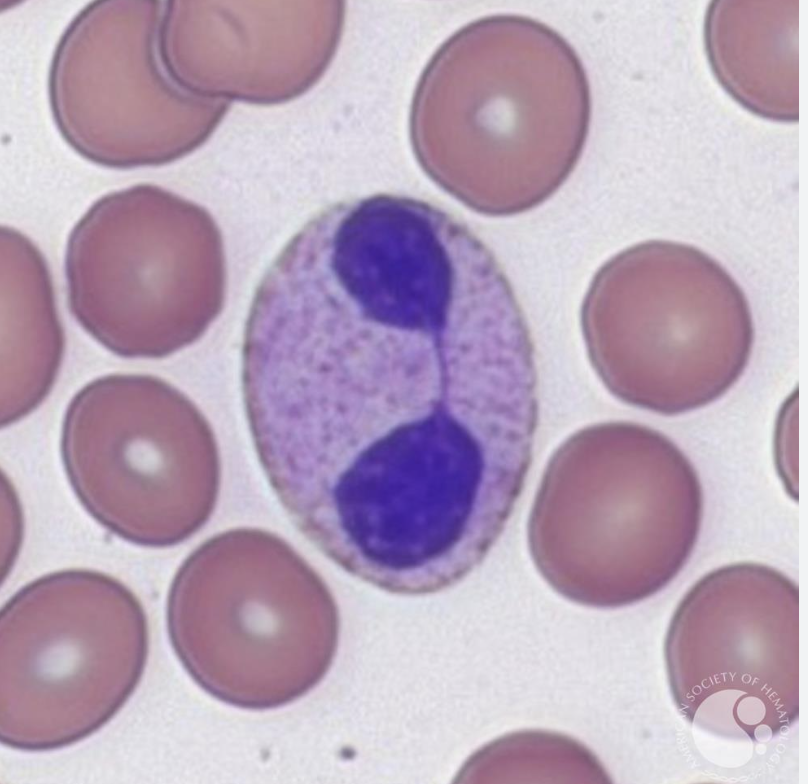

What is Myelodysplastic syndrome?
Group of aquired, haematological stem cells dysorder with
1. Functionally defective blood cells in (but hypercellular) bone marrow
2. Peripheral cytopenia
Also increased risk of progression into malignancy
What morphological features can be seen in MDS?
In
1. Neutrophils
2. Erythrocytes
3. Megakaryocyttes
- Neutrophils: pelger-huet anomality and hypogranularity
- Erytrhocytes: Most common abnormality macrocytosis, but erythroblasts in bone marrow very abnormal (sideroblastics can also occur)
- Dysplastic megakaryocytes (small or hypeolobulated in BMI)
- Increased proportion of blast cells (>5%)
What is Pelger-Huet anomaly?
Neutrophil where two nuclei are connected with very thinck bridge (+Hyposegmentation)
What factors carry a worse prognosis in MDS?
- High BLast cell %
- Poor karyotype
- Low Hb
- Low Platelets
- Low Neutrophils
In MDS, the normal BM is replaced by clonal population of cells derived from a single mutated haematopoietic stemm cell that still proliferates but the cells mature abnormally.
In what ways is maturation abnormal?
- ineffective haemopoiesis (as more haemopoietic precursurs die –> explanation for hypercellular marrow + pancytopenia)
- Abnormal maturation = Dysplasia = myeloDYSPLASTIC syndrome
What are the complications/ problems of Myelodysplasia?
- Deterioration of Blood counts
- Development of AML (5-50%) <1year, depending on sub-type)
- AML from MDS has very poor prognosis, as often few/no normal stem-cells present to regenerate normal haematopoesis
What is typical clinical presentation of Myelodysplasic syndrome?
Usually due to cytopenia, depedant on the cell-lineage involved
1. Erythrocytes: breathlessness, anemaia, pallor
2. WCC: infections
3. Platelets: petechiae
What do pattients with melodysplasia die of?
Complication of cytopenias
* haemorrhoage
* infection etc
or progression to AML
What are curative treatment options of MDS?
Only curative treatment if BM transplant
potentailly intenstive chemotherapy
What is supportive treatment options for MDS?
- Blood product support
- Antimicrobial therapy
- Growth factors (Epo, G-CSF, TPO-Receptor Agonist)
What disease-modyfing medications can be used in the management of MDS?
- Immunosuppressive therapy
- e.g. Lenalidomide for specific sub-type of MDS (due to 5q)
- Oral chemotherapy: hydroxyurea if High WCC (but WCC usually low in MDS )
What place does Chemotherapy play in the treatment of MDS?
Minority of patients, as mainly disease of the elderly and intensive chemotherapy not indicated
What are primary causes of Bone Marrow Failure?
- Genetic Mutations (e.g. Fanconi Anaemia)
- Haematological diseases
What are causes of secondary BM failure?
- BM infiltration (Haematological, non-haematological)
- Radiation
- Drugs
- Chemicals (benzenes)
- Autoimmune
- Infections (Parvovirus, Viral Hepatitis, HIV)
What drugs cause BM failure?

What are the characteristics of aplastic anaemia?
What is the most common Aetiology?
Incidence
- 1/500.000
- Peak incidence 15-24 and >60
Aetiology
70% idiopathics
inherited
* Dyskeratosis congenita, Fanconi anaemia, Schachman-Diamond syndrome
Secondary e.g. malignant infiltration, radiation, chemo
What is the pathophysiolofy of idiopathic Aplastic anaemia?
Failure of BM to produce blood cells: usually problem in stem cells (CD 34) and often auto-immune
How is aplastic anaemia diagnosed?
- Blood count: cytopenia (AA= erythrocytes but can have other cytopenias)
- BM aspirate BM: Hypocellular

What are some diffrentials for Pancytopenia and Hypocellular Marrow?
1. Aplastic anaemia
2. Hypocellular ALL
3. Hypoplastic MDS /AML
4. others very rare
What are the Camitta criteria for diagnosis of Aplastic anaemia?
Need 2/3 of periheral blood features
1. Low reticulocytes
2. Low Neutrophils
3. Low Platelets
AND
Bone Marrow: <25 % cellular
How is BM failure managed?
- Treat cause
- Supportive: Blood product support, ABX +/- iron chelation
- Biological stimmulants (EPO, TPO receptor agonist)
- Immunosuppression in auto-immune causes
- Stem cell transplant

What are treatment option for Idiopathic AA?
- Immunosuppression
- Androgens
- Stem Cell transplant: generally for patients <40 years (prognosis with sibling donor: >70%)
What are complications of immunosuppression in idiopathic AA?
- Relapse (35%)
- Clonal Haematological disorders
- Sold tumour risk ~3%
What is Fanconi anaemia?
Most common cause of inherited aplastic anaemia
Autosomal recessive or X-linked inheritence of DNA cross-link repair defect
Several genes are associated with it





